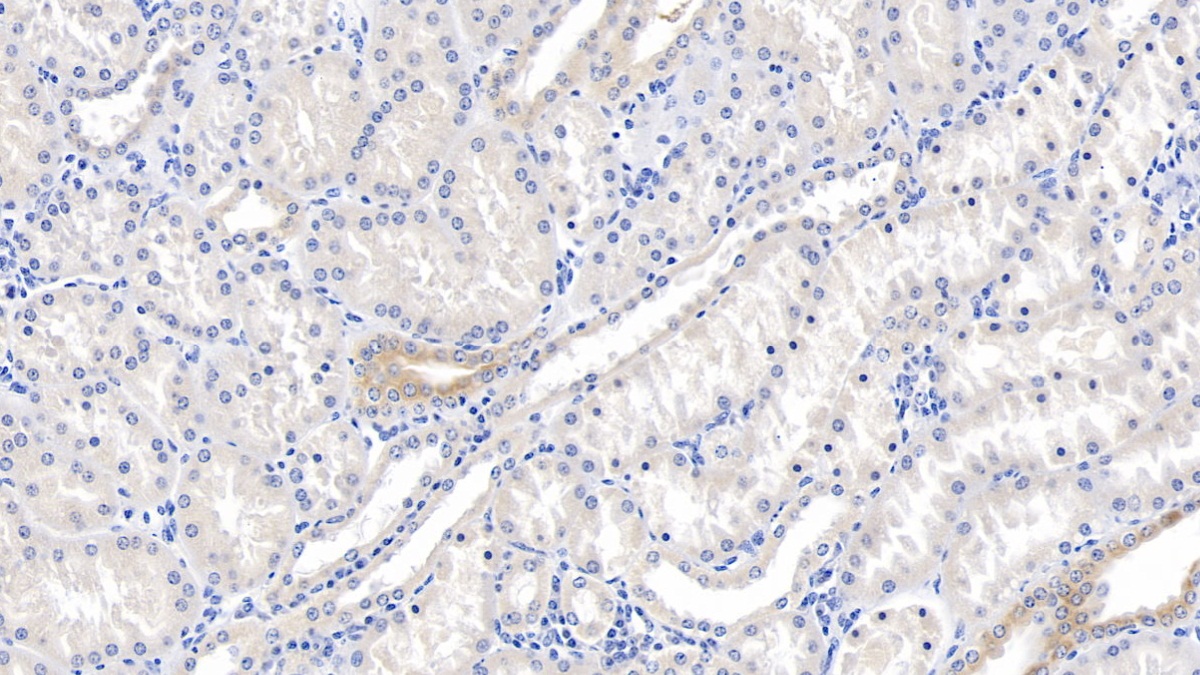
https://d1vffmuvmgkypt.cloudfront.net/image/ridacom_ltd/cloud_clone_corp/PRODUCT_SOURCE__CLOUD_CLONE__SUPPLIER__RIDACOM__ID__PAC813Hu01__1

Antigen
LAM
Reactivity
Human
(6)
Mouse
(2)
Rat
(2)
Preparation method
Escherichia coli
(1)
Human
(1)
Application
Enzyme-linked immunosorbent assay for Antigen Detection
(4)
Chemiluminescent immunoassay for antigen detection
(3)
Western Blotting
(3)
Positive Control
(2)
SDS-PAGE
(2)
Immunocytochemistry
(1)
Immunohistochemistry
(1)
Immunoprecipitation
(1)
Category
ELISA Kits
(7)
Cell biology
(2)
Immunochemicals
(2)
Protein Biochemistry
(2)
Antibodies
(1)
CLIA Kit for Laminin (LN)
$638.00
| 48T | $638.00 | |
| 96T | $912.00 | |
| 96T*5 | $4,104.00 |
| 96T*10 | $7,752.00 | |
| 96T*100 | $63,840.00 |
CLIA Kit for Laminin (LN)
$605.00
| 48T | $605.00 | |
| 96T | $864.00 | |
| 96T*5 | $3,888.00 |
| 96T*10 | $7,344.00 | |
| 96T*100 | $60,480.00 |
CLIA Kit for Laminin (LN)
$588.00
| 48T | $588.00 | |
| 96T | $840.00 | |
| 96T*5 | $3,780.00 |
| 96T*10 | $7,140.00 | |
| 96T*100 | $58,800.00 |
| 48T | $485.00 | |
| 96T | $693.00 | |
| 96T*5 | $3,119.00 |
| 96T*10 | $5,891.00 | |
| 96T*100 | $48,510.00 |
ELISA Kit for Laminin (LN)
$479.00
| 48T | $479.00 | |
| 96T | $684.00 | |
| 96T*5 | $3,078.00 |
| 96T*10 | $5,814.00 | |
| 96T*100 | $47,880.00 |
ELISA Kit for Laminin (LN)
$441.00
| 48T | $441.00 | |
| 96T | $630.00 | |
| 96T*5 | $2,835.00 |
| 96T*10 | $5,355.00 | |
| 96T*100 | $44,100.00 |
ELISA Kit for Laminin (LN)
$403.00
| 48T | $403.00 | |
| 96T | $576.00 | |
| 96T*5 | $2,592.00 |
| 96T*10 | $4,896.00 | |
| 96T*100 | $40,320.00 |

Antigen:
Reactivity:Human
Application:Positive Control; SDS-PAGE; Western Blotting
Research area:Tumor immunity
Preparation method:Escherichia coli
| 10µg | $200.00 | |
| 50µg | $500.00 | |
| 200µg | $1,000.00 |
| 1mg | $3,000.00 | |
| 5mg | $7,500.00 |
Antigen:
Host:Rabbit
Reactivity:Human
Application:Western Blotting; Immunohistochemistry; Immunocytochemistry; Immunoprecipitation
Clonality:Polyclonal
Research area:Tumor immunity
| 20µl | $87.00 | |
| 100µl | $203.00 | |
| 200µl | $290.00 |
| 1ml | $725.00 | |
| 10ml | $2,900.00 |
Native Laminin (LN)
$80.00
| 10µg | $80.00 | |
| 50µg | $200.00 | |
| 200µg | $400.00 |
| 1mg | $1,200.00 | |
| 5mg | $3,000.00 |




-SCA082Ra-000001.png)



-SCA082Mu-000001.png)






-HEA082Hu-000001.png)



-SEA082Ra-000001.png)



-SEA082Hu-000001.png)



-SEA082Mu-000001.png)

-RPC813Hu01-000001.png)



-NPA082Hu01-000001.png)